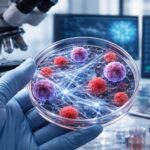
découvrez comment le collagène et les cancers hormono-dépendants impactent les traitements modernes, en explorant les avancées scientifiques et les nouvelles stratégies thérapeutiques.

L’anatomie humaine est fascinante et complexe, un véritable chef-d’œuvre de l’évolution naturelle. Chaque partie du corps joue un rôle crucial, et même parmi les organes les moins connus, on découvre des merveilles insoupçonnées. Dans cet article, nous allons examiner les différentes parties du corps qui commencent par la lettre « O », en mettant en lumière leur structure, leur fonction, et d’autres aspects importants. Préparez-vous à une exploration intrigante, enrichie d’anecdotes et d’exemples concrets.
Le rôle essentiel de l’oreille dans l’audition
L’oreille, un organe complexe, joue un rôle fondamental dans notre capacité à entendre. Elle est divisée en trois parties principales : l’oreille externe, l’oreille moyenne, et l’oreille interne. Chaque section remplit une fonction spécifique qui contribue à notre perception des sons.
Oreille externe
L’oreille externe est constituée du pavillon et du conduit auditif. Le pavillon, visible à l’extérieur, capte les ondes sonores et les dirige vers le conduit auditif. Cette partie du corps est également impliquée dans la localisation des sons. Par exemple, les personnes peuvent souvent déterminer d’où vient un bruit simplement par la manière dont il atteint leur oreille.
- Pavillon : structure en cartilage qui capte les sons.
- Conduit auditif : tube menant au tympan qui amplifie les sons.
Oreille moyenne
Une fois les ondes sonores atteignant le tympan, l’oreille moyenne entre en jeu. Elle contient les osselets—le marteau, l’enclume et l’étrier—qui amplifient les vibrations sonores avant qu’elles n’atteignent l’oreille interne. Ces petits os sont si efficaces qu’ils permettent d’augmenter le son d’environ 20 fois !
Oreille interne
L’oreille interne, quant à elle, est responsable de notre équilibre et de notre audition. Elle contient la cochlée, un organe en forme de spirale rempli de liquide, qui transforme les vibrations en signaux nerveux que le cerveau interprète comme des sons. Une défaillance de cette partie peut entraîner des troubles tels que la surdité ou des déséquilibres. Des études montrent que près de 5 % de la population mondiale souffre de troubles auditifs liés à des défaillances de l’oreille interne.

Les implications de l’oesophage dans la digestion
L’œsophage est le tube musculaire qui relie la bouche à l’estomac. En tant que partie intégrante du système digestif, il a pour rôle principal de transporter les aliments, mélangés à des salives, depuis la cavité buccale jusqu’à l’estomac pour une digestion ultérieure. Cette action se fait par le biais de contractions musculaires appelées péristaltisme.
Anatomie de l’œsophage
L’œsophage mesure environ 25 centimètres de long chez l’adulte moyen. Sa structure est composée de plusieurs couches musculeuses qui permettent le mouvement des aliments. Un fait intéressant est que l’œsophage est capable de s’étirer pour accueillir des aliments de différentes tailles.
- Couche muqueuse : tapisse l’intérieur de l’œsophage, protège et lubrifie.
- Couche musculaire : composée de muscles longitudinaux et circulaires qui permettent le péristaltisme.
Fonctions et troubles de l’œsophage
Outre le transport, l’œsophage joue également un rôle dans la déglutition. Des troubles tels que le reflux gastro-œsophagien (RGO) peuvent provoquer des brûlures d’estomac. En 2025, il est estimé que 20 % de la population souffrira d’une forme de RGO à un moment donné de sa vie. Cela met en lumière l’importance de suivre une alimentation équilibrée et d’être conscient de nos habitudes alimentaires.

Ombilical et son héritage physiologique
Le terme « ombilical » fait référence à la région entourant le nombril, la cicatrice qui reste après la coupure du cordon ombilical à la naissance. Ce cordon, pendant la grossesse, est vital pour le transport de nutriments et d’oxygène de la mère au fœtus.
Le cordon ombilical
Le cordon ombilical est composé de deux artères et d’une veine. Ces vaisseaux sanguins sont essentiels pour nourrir le fœtus et assurer son développement. Au moment de la naissance, le cordon est coupé, laissant l’ombilic comme un souvenir de cette connexion vitale.
Le cordon ombilical joue un rôle tellement crucial que des recherches actuelles explorent même l’utilisation des cellules souches issues de celui-ci pour traiter différentes maladies.
Les infections ombilicales
Malheureusement, l’ombilic peut également être sujet à diverses infections. Les soins appropriés lors de la période néonatale sont essentiels. Environ 7% des nouveau-nés peuvent rencontrer des complications liées à des infections ombilicales. Une hygiène précise est donc primordiale pour éviter ces problèmes, vu que des bactéries peuvent facilement s’introduire dans le corps à travers cette zone sensible.
Structures osseuses : l’importance des os vivants
Les os sont souvent considérés comme des structures rigides, mais ils sont en réalité des éléments vivants de notre corps. L’os est composé de cellules vivantes et de tissu conjonctif, ce qui le rend dynamique et capable de se réparer et de se remodeler. Pensons à des os vifs, comme ceux des bras ou des jambes, qui, grâce à leur dynamique, soutiennent notre corps.
Anatomie des os
Chaque os est composé de deux types principaux de tissu : le tissu osseux spongieux et le tissu osseux compact. Le tissu spongieux est léger et contribue à la production des cellules sanguines, tandis que le tissu compact, plus dense, offre un soutien structurel.
| Tissu Osseux | Caractéristiques | Fonction |
|---|---|---|
| Tissu Spongieux | Léger, rempli de moelle osseuse | Production de cellules sanguines |
| Tissu Compact | Dense, solide | Soutien structural |
Remodelage osseux
Le processus de remodelage des os est constant et vital pour la santé. En effet, des facteurs comme l’exercice physique et l’alimentation riche en calcium influencent cette dynamique. Des études indiquent que les sportifs, par exemple, ont des os plus robustes que ceux menant une vie sédentaires.
Le rôle de l’olfaction dans la perception sensorielle
Le terme « olfactif » se réfère au sens de l’odorat, l’un des sens les plus puissants de l’être humain. Le nez, grâce à ses récepteurs olfactifs, permet la détection d’une multitude d’odeurs qui influencent nos émotions et comportements au quotidien.
Anatomie du système olfactif
Le système olfactif est constitué de plusieurs structures, dont la cavité nasale et le bulbe olfactif. La cavité nasale arbore de nombreuses terminaisons nerveuses qui réagissent aux molécules odorantes, et le bulbe olfactif est responsable de leur interprétation.
- Cavité nasale : où les molécules odorantes sont captées.
- Bulbe olfactif : interprète les signaux envoyés au cerveau.
Influence des odeurs sur le comportement
Les odeurs ont un impact significatif sur notre mémoire et notre humeur. Par exemple, des études montrent que certaines fragrances peuvent rappeler des souvenirs d’enfance ou créer une ambiance apaisante. Les parfumeries exploitent cette connexion à travers des gammes olfactives qui éveillent des émotions variées.
Utilisation des onguents pour la santé de la peau
Les onguents sont des préparations topiques appliquées sur la peau pour traiter divers problèmes cutanés. De la simple hydratation à des solutions médica.ux avancées, leur importance ne peut être négligée.
Différents types d’onguents
Il existe une variété d’onguents disponibles, chacun ayant sa propre fonction spécifique. Les onguents antibactériens, par exemple, sont utilisés pour traiter les infections, tandis que les onguents hydratants apportent un soulagement aux peaux sèches. Analyser ces distinctions est essentiel pour garantir un soin optimal de la peau.
| Type d’Onguents | Utilisation | Exemples |
|---|---|---|
| Antibactériens | Traiter les infections cutanées | Bactroban, Neosporin |
| Hydratants | Soulager la peau sèche | Cérat de Galien, Crème Nivéa |
Précautions d’utilisation
Bien que les onguents offrent de nombreux bénéfices, il est crucial de respecter les consignes d’utilisation pour éviter des réactions allergiques ou des aggravations de l’état cutané. Par exemple, un usage excessif de certains onguents peut entraîner des irritations.
L’omoplate et son importance pour la mobilité
Située à l’arrière du thorax, l’omoplate facilite beaucoup de nos mouvements quotidiens. Elle joue également un rôle crucial dans l’articulation de l’épaule et maintient la connexion entre l’humérus et le reste du corps.
Fonction de l’omoplate dans le mouvement
L’omoplate est connectée à plusieurs muscles qui permettent des mouvements variés des bras et des épaules. Des exercices spécifiques peuvent renforcer ces muscles et améliorer notre mobilité. Par ailleurs, les sportifs, en particulier ceux pratiquant des activités de type « omoplate sport », bénéficient d’une attention particulière pour maintenir la force et la flexibilité de cet os.
Les blessures courantes de l’omoplate
Avec les activités physiques, des blessures liées à l’omoplate, comme les tendinites ou les fractures, peuvent se produire. Un diagnostic rapide et un traitement approprié sont essentiels. Prendre soin de ces zones sensibles permet de prévenir des douleurs chroniques ou des limitations de mouvements dans le futur.
Récapitulatif : Les parties du corps commençant par « O »
Jusqu’ici, nous avons exploré divers éléments fascinants, allant de l’oreille à l’omoplate. Chacune de ces structures contribue à notre fonction corporelle quotidienne, rappelant l’énorme complexité de notre anatomie. La compréhension de ces parties peut non seulement améliorer notre santé, mais aussi notre performance quotidienne.
- Oreille : audition et équilibre.
- Oesophage : transport des aliments.
- Ombilical : héritage néonatal.
- Os : soutien et mobilité.
- Olfaction : lien émotionnel.
- Onguent : soin de la peau.
- Omoplate : mobilité de l’épaule.
Mieux comprendre ces éléments nous rapproche d’une meilleure connaissance de notre corps et de son fonctionnement, établissant ainsi un lien entre notre anatomie et notre bien-être général.
Des questions courantes sur l’anatomie des parties du corps
À mesure que nous terminons cette exploration des parties du corps débutant par la lettre « O », il est utile de se poser quelques questions fréquentes pour clarifier certains points. Voici quelques questions souvent posées :
1. Quelle est la fonction principale de l’oreille?
Elle permet l’audition et la perception de l’équilibre.
2. Comment l’œsophage participe-t-il à la digestion?
Il transporte les aliments de la bouche à l’estomac grâce à des contractions musculaires.
3. Quelles sont les implications de l’ombilical post-natale?
Il marque l’endroit où le cordon ombilical était attaché, un lien historique avec la mère.
4. Pourquoi les os sont-ils considérés comme des tissus vivants?
Parce qu’ils se réparent et se remodèlent en fonction de l’activité physique et de l’alimentation.
5. Comment l’olfaction influence-t-elle notre comportement?
Les odeurs peuvent évoquer des souvenirs et influencer notre humeur.